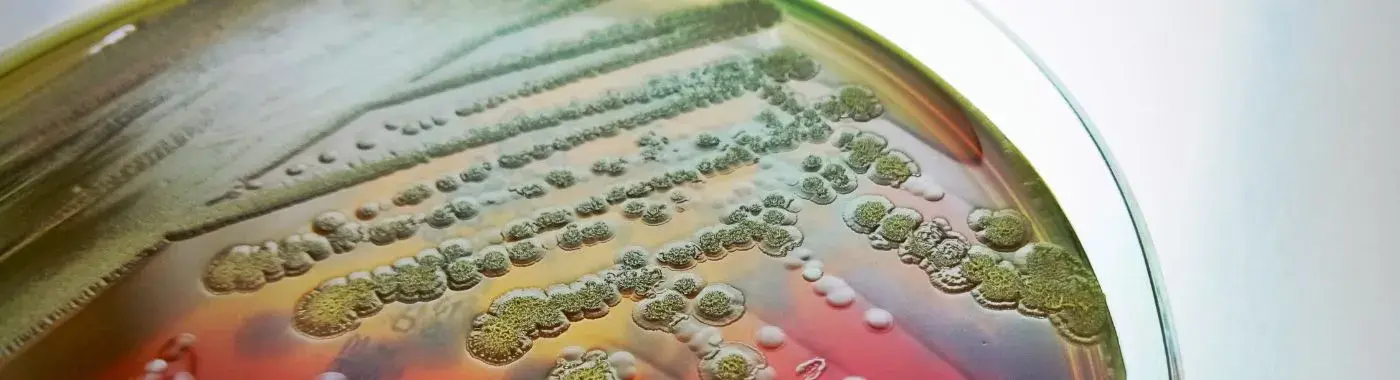
Bacteremia - Causes, Symptoms, Diagnosis, Treatment, and Prevention

- Home
- Treatments & Procedures
- Capsule Endoscopy - Cost, Indi...
Bacteremia - Causes, Symptoms, Diagnosis, Treatment, and Prevention
Understanding Bacteremia: A Comprehensive Guide
Introduction
Bacteremia is a medical condition characterized by the presence of bacteria in the bloodstream. While it may sound alarming, it is essential to understand its significance, causes, symptoms, and treatment options. Bacteremia can lead to severe health complications, including sepsis, if not diagnosed and treated promptly. This article aims to provide a comprehensive overview of bacteremia, making it accessible for a general audience while ensuring medical accuracy.
Definition
What is Bacteremia?
Bacteremia refers to the presence of viable bacteria in the bloodstream. It can occur transiently, such as after dental procedures or vigorous exercise, or it can be persistent, indicating a more serious underlying infection. The condition can lead to systemic infections and is often a precursor to sepsis, a life-threatening response to infection. Understanding bacteremia is crucial for recognizing its potential impact on health and the importance of timely medical intervention.
Causes and Risk Factors
Infectious/Environmental Causes
Bacteremia can arise from various infectious agents, including:
- Bacteria: Common bacteria that can cause bacteremia include Staphylococcus aureus, Escherichia coli, and Streptococcus pneumoniae. These bacteria can enter the bloodstream through various routes, such as skin infections, urinary tract infections, or pneumonia.
- Environmental Factors: Certain environmental factors, such as poor sanitation and exposure to contaminated water or food, can increase the risk of infections that may lead to bacteremia.
Genetic/Autoimmune Causes
While bacteremia is primarily caused by infections, some individuals may have genetic predispositions or autoimmune conditions that increase their susceptibility. For example:
- Genetic Disorders: Conditions that affect the immune system, such as congenital immunodeficiencies, can make individuals more vulnerable to infections.
- Autoimmune Diseases: Diseases like lupus or rheumatoid arthritis can compromise the immune system, increasing the risk of bacteremia.
Lifestyle and Dietary Factors
Certain lifestyle choices and dietary habits can contribute to the risk of developing bacteremia:
- Poor Nutrition: A diet lacking essential nutrients can weaken the immune system, making it harder for the body to fight off infections.
- Substance Abuse: Alcohol and drug abuse can impair immune function and increase the likelihood of infections.
- Hygiene Practices: Poor hygiene, such as inadequate handwashing or neglecting dental care, can lead to infections that may result in bacteremia.
Key Risk Factors
Several factors can increase the risk of developing bacteremia:
- Age: Infants and the elderly are at higher risk due to immature or weakened immune systems.
- Gender: Some studies suggest that men may be at a slightly higher risk than women.
- Geographic Location: Certain regions may have higher incidences of specific infections that can lead to bacteremia.
- Underlying Conditions: Chronic illnesses such as diabetes, cancer, or liver disease can compromise the immune system, increasing susceptibility to infections.
Symptoms
Common Symptoms of Bacteremia
The symptoms of bacteremia can vary widely, but common signs include:
- Fever: A high fever is often one of the first signs of bacteremia.
- Chills: Patients may experience chills or shivering.
- Rapid Heart Rate: An increased heart rate can occur as the body responds to infection.
- Fatigue: Generalized weakness and fatigue are common.
- Nausea and Vomiting: Some individuals may experience gastrointestinal symptoms.
Warning Signs for Immediate Medical Attention
Certain symptoms indicate the need for immediate medical attention:
- Severe Fever: A fever above 101°F (38.3°C) that does not respond to over-the-counter medications.
- Confusion or Disorientation: Changes in mental status can indicate severe infection.
- Difficulty Breathing: Shortness of breath or difficulty breathing should be addressed immediately.
- Severe Pain: Unexplained or severe pain, especially in the abdomen or chest, warrants urgent evaluation.
Diagnosis
Clinical Evaluation
The diagnosis of bacteremia begins with a thorough clinical evaluation, including:
- Patient History: The healthcare provider will ask about symptoms, recent infections, medical history, and any risk factors.
- Physical Examination: A physical exam may reveal signs of infection, such as fever, rash, or localized pain.
Diagnostic Tests
Several diagnostic tests are used to confirm bacteremia:
- Blood Cultures: The primary test for diagnosing bacteremia involves taking blood samples to culture and identify the bacteria present.
- Complete Blood Count (CBC): A CBC can help assess the overall health of the patient and detect signs of infection.
- Imaging Studies: In some cases, imaging studies like X-rays or CT scans may be necessary to identify the source of infection.
Differential Diagnosis
It is essential to differentiate bacteremia from other conditions that may present with similar symptoms, such as:
- Viral Infections: Conditions like influenza or COVID-19 can mimic bacteremia symptoms.
- Fungal Infections: Fungal infections can also lead to similar systemic symptoms.
- Non-Infectious Conditions: Conditions such as autoimmune diseases or malignancies may present with fever and fatigue.
Treatment Options
Medical Treatments
The treatment of bacteremia typically involves:
- Antibiotics: The primary treatment for bacteremia is the administration of appropriate antibiotics, which may be adjusted based on the results of blood cultures.
- Intravenous Fluids: Patients may require IV fluids to maintain hydration and support blood pressure.
- Surgical Intervention: In cases where an abscess or infected tissue is identified, surgical drainage may be necessary.
Non-Pharmacological Treatments
In addition to medical treatments, certain lifestyle modifications can support recovery:
- Rest: Adequate rest is crucial for recovery.
- Hydration: Staying well-hydrated helps the body fight infection.
- Nutrition: A balanced diet rich in vitamins and minerals can support immune function.
Special Considerations for Different Populations
- Pediatric Patients: Children may require different dosages of antibiotics and careful monitoring for side effects.
- Geriatric Patients: Older adults may have different responses to infections and treatments, necessitating a tailored approach.
Complications
Potential Complications of Untreated Bacteremia
If left untreated, bacteremia can lead to severe complications, including:
- Sepsis: A life-threatening condition characterized by a systemic inflammatory response to infection.
- Organ Failure: Prolonged bacteremia can result in failure of vital organs, such as the kidneys, liver, or lungs.
- Endocarditis: Infection of the heart valves can occur, leading to serious cardiovascular complications.
Short-Term and Long-Term Complications
- Short-Term: Immediate complications may include septic shock, which can be fatal without prompt treatment.
- Long-Term: Survivors of severe bacteremia may experience long-term health issues, including chronic fatigue or organ dysfunction.
Prevention
Strategies for Preventing Bacteremia
Preventing bacteremia involves several strategies:
- Vaccinations: Staying up-to-date with vaccinations can help prevent infections that may lead to bacteremia.
- Hygiene Practices: Regular handwashing and proper dental care can reduce the risk of infections.
- Dietary Modifications: A balanced diet rich in fruits, vegetables, and whole grains supports immune health.
- Lifestyle Changes: Avoiding smoking and excessive alcohol consumption can strengthen the immune system.
Prognosis & Long-Term Outlook
Typical Course of the Disease
The prognosis for bacteremia largely depends on the underlying cause, the patient's overall health, and the timeliness of treatment. With prompt diagnosis and appropriate treatment, many individuals recover fully.
Factors Influencing Prognosis
Several factors can influence the overall prognosis:
- Early Diagnosis: Early identification and treatment of bacteremia significantly improve outcomes.
- Adherence to Treatment: Following medical advice and completing prescribed antibiotic courses are crucial for recovery.
Frequently Asked Questions (FAQs)
- What are the common symptoms of bacteremia? Common symptoms include fever, chills, rapid heart rate, fatigue, and nausea. If you experience severe symptoms like confusion or difficulty breathing, seek medical attention immediately.
- How is bacteremia diagnosed? Bacteremia is diagnosed through blood cultures, complete blood counts, and sometimes imaging studies to identify the source of infection.
- What causes bacteremia? Bacteremia can be caused by various bacteria entering the bloodstream through infections, environmental factors, or compromised immune systems.
- How is bacteremia treated? Treatment typically involves antibiotics, intravenous fluids, and sometimes surgical intervention to address the source of infection.
- Can bacteremia be prevented? Yes, bacteremia can be prevented through vaccinations, good hygiene practices, and a healthy lifestyle.
- What are the complications of untreated bacteremia? Untreated bacteremia can lead to severe complications such as sepsis, organ failure, and endocarditis.
- Who is at higher risk for bacteremia? Individuals with weakened immune systems, chronic illnesses, the elderly, and infants are at higher risk for developing bacteremia.
- How long does recovery from bacteremia take? Recovery time varies depending on the severity of the infection and the individual's overall health, but many people recover fully with appropriate treatment.
- Are there any long-term effects of bacteremia? Some individuals may experience long-term effects, such as chronic fatigue or organ dysfunction, especially if the bacteremia was severe.
- When should I see a doctor for bacteremia symptoms? Seek medical attention if you experience severe fever, confusion, difficulty breathing, or severe pain, as these may indicate a serious infection.
When to See a Doctor
It is crucial to seek immediate medical attention if you experience any of the following:
- Severe fever above 101°F (38.3°C)
- Confusion or disorientation
- Difficulty breathing or shortness of breath
- Severe pain, especially in the abdomen or chest
Conclusion & Disclaimer
Bacteremia is a serious medical condition that requires prompt diagnosis and treatment. Understanding its causes, symptoms, and treatment options can empower individuals to seek timely medical care. By adopting preventive measures, we can reduce the risk of developing bacteremia and its associated complications.
Disclaimer: This article is for informational purposes only and does not replace professional medical advice. Always consult a healthcare provider for medical concerns or questions regarding your health.


 Best Hospital Near me Chennai
Best Hospital Near me Chennai

